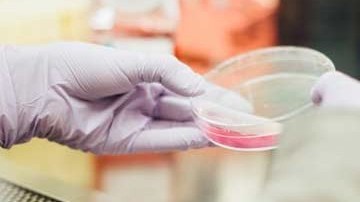
wrappixel kit

Locate centers
Find center near you
Find a Test
View Test and Prices
Health Packages
View Health Bundles
Upload Prescription
Upload Doctors Prescription
Announcements of SIDC
Stay informed with the latest health news, important updates, and advancements in diagnostic technology. We share timely and clear information to help you stay informed and confident in your healthcare journey.
Experienced Team of Doctors
Our team of skilled and compassionate doctors is dedicated to delivering accurate diagnoses and personalized care you can always trust and rely on, ensuring your health and well-being are our top priorities.
Health Packages & Pricing
We offer 100% satisfaction with our health packages, ensuring quality service and trusted results. We’re committed to addressing your concerns and ensuring a better, more personalized healthcare experience.
Total Care Checkup
- Service Timings :30 mins
- Visit Type :1
- Reporting TAT :Same Day
- Morning and Evening Checking
Basic Care Health Package
- Service Timings :15 mins
- Visit Type :1
- Reporting TAT :Same Day
- Morning and Evening Checking
Facilities
You can relay on our amazing features list and also our customer services will be great experience.
Online Appointment
You can relay on our amazing features list and also our customer services will be great experience.
Latest Technologies
You can relay on our amazing features list and also our customer services will be great experience.
Experienced Team
You can relay on our amazing features list and also our customer services will be great experience.
Services at SIDC
You can relay on our amazing features list and also our customer services will be great experience for you without doubt and in no-time
At SIDC, our scan services use advanced medical imaging technology—including ultrasound, CT, and MRI—to deliver precise and detailed insights into your health. Every scan is performed with expert care, ensuring comfort, accuracy, and support throughout your healthcare journey.
Learn more
Our Laboratory (Lab) department is equipped with modern technology and managed by experienced professionals to deliver precise and timely diagnostic services. We offer a comprehensive range of tests including blood analysis, pathology, microbiology, biochemistry, and specialized investigations.
With a strong focus on quality control and accuracy, our lab follows standardized procedures to ensure reliable results for patients and healthcare providers. We maintain strict hygiene protocols, use advanced equipment, and implement continuous monitoring systems to uphold the highest standards of medical diagnostics.
Our goal is to support early detection, effective treatment planning, and improved patient outcomes through dependable laboratory services.
Learn more